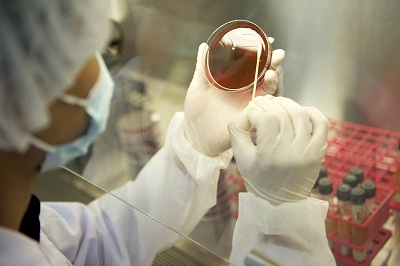

本质团队一直坚持发布中国直销拿牌企业年度报告供业界参考,至今已有21年。请戳系列回顾。 这是《2026年度中国直销企业发展报告》第十篇,重点盘点了云尚、致中和、中脉、铸源、紫祥科技、自然阳光六家拿牌直销企业的发展现状。 81.云尚 公司情况...【详情】
发布人:本小点来源:安利 发布时间:2014-08-20 11:12

今年是纽崔莱品牌创立80周年。80年来,纽崔莱以其卓越的产品品质和健康理念,不但赢得了全球消费者的高度信赖,而且四度签约中国奥委会,成为中国奥运代表团专用营养保健食品。值此纽崔莱80周年庆典到来前夕,中国奥委会特意发来贺函,对纽崔莱为中国奥林匹克运动发展所做出的贡献表示崇高敬意和诚挚感谢。以下为贺函全文:

欣闻今年是纽崔莱品牌创立八十周年,作为安利纽崔莱多年合作伙伴,特此致贺。
中国奥委会与安利纽崔莱的合作从2000年悉尼奥运会开始,迄今已逾14个年头。一直以来,纽崔莱以其安全可靠的卓越品质,在运动员的营养补充方面发挥了重要作用。在此,中国奥委会也对安利纽崔莱为中国奥林匹克运动发展所做出的贡献表示崇高的敬意和诚挚的感谢!
安利纽崔莱的品牌精髓是“自然的精华,科学的精粹”,在考察纽崔莱品牌的过程中,中国奥委会深刻感受到了安利各部门对这一理念全方位的贯彻,对纽崔莱从种子到成品全程品质管控的高水平实践深表钦佩。作为2016和2020年奥运会中国体育代表团营养保健食品合作伙伴,相信安利纽崔莱将为中国体育健儿带来更充沛的营养动力。
八十周年意味着厚重的品牌底蕴,也意味着更高的起点。相信纽崔莱产品将得到越来越多消费者的认可,也衷心祝愿安利纽崔莱在中国市场取得更优异的成绩!
可以说,每一块闪闪的奥运金牌,都是对纽崔莱的最高褒奖。那么,纽崔莱何以能够得到中国奥委会的青睐,又经过了哪些“天王级选秀”,让我们一起走进纽崔莱的“冠军之路”。
奥运标准:比普通食品严苛300倍
中国奥委会对运动员使用的营养保健食品比普通食品严格300倍。纽崔莱能够成为中国奥运体育代表团专用营养保健品,必须经过国家反兴奋剂检测中心的严格检测。并在定期送检中持续符合测试中心不断改进的检测指标和要求。
营养指导:为奥运健儿提供营养方案

在备战伦敦奥运期间,纽崔莱还为中国奥运健儿提供运动营养指导和个性化运动营养解决方案,并为代表团膳食营养专业人员提供运动营养培训。
冠军评价:纽崔莱提供营养助力

田亮、刘翔、陈一冰、孙杨等诸多奥运冠军过去都曾表示,在夺金斩银的辉煌之路背后,离不开纽崔莱的鼎力支持。
陈一冰曾表示纽崔莱蛋白粉、倍立健等确实在营养方面给予了体操队很全面的保障和支持。
刘翔也曾谈到在备战伦敦奥运会期间,营养诀窍就是早餐冲泡牛奶时加几勺纽崔莱蛋白粉。自己对草莓口味的蛋白粉情有独钟。
田亮也曾指出纽崔莱让他展现出最完美状态。
从2014年9月起,纽崔莱蛋白粉全线产品标注“非转基因大豆分离蛋白”标识

纽崔莱®多种植物蛋白粉,一直采用非转基因大豆分离蛋白作为主要原料。该产品经具有合法资质的检测机构检测,确认不含转基因成分。为了满足消费者需求,纽崔莱包括多种植物蛋白粉在内的所有含大豆分离蛋白的产品,将从2014年9月份起陆续在外包装上增加“非转基因大豆分离蛋白”的标识。
对于一个负责任的保健品企业而言,做好保健食品要比做药更难。因为做药主要关注的是功效,允许有一定的毒副作用。而保健食品是食品,安全性是放在第一位的。为充分保障产品的安全性,安利全球研发体系中设有一个专门的产品安全性评估团队,甚至包括专职的毒理专家。在保健食品行业中,有毒理专家的企业可谓凤毛麟角。
权威认证:获得全球最严格食品安全认证

纽崔莱拥有多项世界级认证,其中包括英国标准协会(BSI)颁发的HACCP食品安全认证证书(后升级为ISO22000:2005证书),该认证的获得者可使用代表欧盟最高规格食品安全管理认证的PvA标志,表明纽崔莱的食品安全体系符合业内最严格的管理标准。除此之外,纽崔莱还顺利通过GMP中国生产质量认证和ISO服务质量认证。
安全测试:每月超过25000次
纽崔莱实行“种子到成品”全程严密质量管控,每个月要进行25000多次产品测试,而每一批产品要通过300余种质量测试,确保产品安全性。
【免责声明】本网站未标有“原创”的稿件均为转载稿。如转载稿涉及版权等问题,请联系本站。
相关新闻:
评论专区:(所有评论)有0条评论

